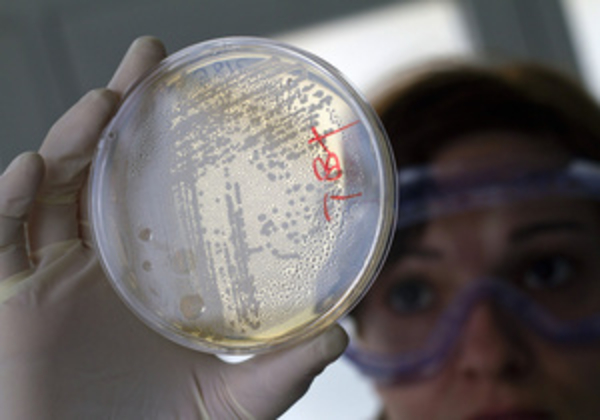
В Японии шесть человек умерли, отравившись маринованной капустой

В Японии шесть человек умерли, отравившись маринованной капустой
Зараженная E.coli капуста производилась и продавалась в префектуре Хоккайдо. Как сообщает агентство Ассошиэйтед Пресс со ссылкой на местные власти, жертвами опасного вируса стали в основном пожилые люди, однако среди погибших оказалась и четырехлетняя девочка.
Маринованная пекинская капуста - популярный в Японии гарнир, ранее в стране не было зафиксировано случаев заражения этим продуктом. Власти префектуры начали расследование инцидента. Возможной причиной заражения продукта могла стать недостаточная стерилизация тары.
Читай также: Отравление: Первая помощь
В 2011 году опасная кишечная инфекция, вызванная редким штаммом бактерии E.coli, унесла жизни более 50 человек в Европе. Всемирная организация здравоохранения (ВОЗ) сообщала, что заболевания зафиксированы в 16 странах.






